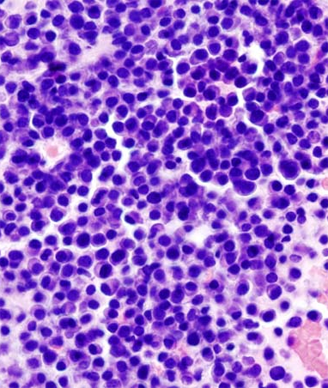

Multiple myeloma patients had better overall survival if they had prior knowledge of having monoclonal gammopathy of undetermined significance.
Micrograph showing multiple myeloma; source: KGH, Wikimedia Commons
Patients with multiple myeloma had better overall survival if they had prior knowledge of having monoclonal gammopathy of undetermined significance (MGUS), a precursor state of the disease. However, patients with MGUS who had progressed to multiple myeloma also had a significantly higher rate of comorbidities compared to those with no prior knowledge of MGUS, according to the results of a study published in JAMA Oncology.
“Our results reflect the importance of lifelong follow-up for individuals diagnosed as having MGUS, independent of risk score, and highlight the need for better risk models based on the biology of the disease,” wrote Elin Edda Sigurdardottir, BS, of the University of Iceland, and colleagues. “Patients should receive balanced information stressing not only the overall very low risk of progression to malignant neoplasm but also the symptoms that could signal such development and the need to consult their physician.”
The population-based study included 14,798 patients diagnosed with multiple myeloma in Sweden between 1976 and 2005, with follow-up until 2007. Of these patients, 2.7% were identified as having prior knowledge of having MGUS.
Those patients with multiple myeloma and prior knowledge of MGUS had a significantly improved overall survival compared with patients with no prior knowledge (HR = 0.86; 95% CI, 0.77-0.96). The median overall survival for those with prior MGUS knowledge was 2.8 years compared with 2.1 years for those without prior knowledge. In addition, data from an analysis looking at cause-specific survival showed that patients with prior MGUS knowledge had a lower risk of dying compared to those patients without prior MGUS knowledge.
The researchers also found that among patients with prior MGUS knowledge an M-protein concentration of less than 5 g/dL was associated with a poorer overall survival (HR = 1.86; 95% CI, 1.13-3.04).
“In models focusing on the impact of comorbidities at diagnosis of multiple myeloma in relation to prior knowledge of MGUS, we found autoimmune diseases, infections, nonhematological malignant diseases, ischemic heart disease, heart failure, cerebrovascular diseases, and renal diseases to be significantly more common in multiple myeloma patients with prior knowledge of MGUS,” the researchers wrote.
In an editorial published with the article, Robert A. Kyle, MD, and S. Vincent Rajkumar, MD, of the Mayo Clinic, Rochester, Minn., wrote: “It cannot be determined whether multiple myeloma patients with a known MGUS in the Icelandic study were followed more closely than those in whom a MGUS was not recognized, and hence it is difficult to attribute a causal relationship between follow-up and better prognosis.”
The editorial authors noted that it was “interesting that patients with a lower M-protein concentration were found to have shorter survival,” but pointed out that it was not possible to “determine any causal relationship” from the study.
Navigating AE Management for Cellular Therapy Across Hematologic Cancers
A panel of clinical pharmacists discussed strategies for mitigating toxicities across different multiple myeloma, lymphoma, and leukemia populations.